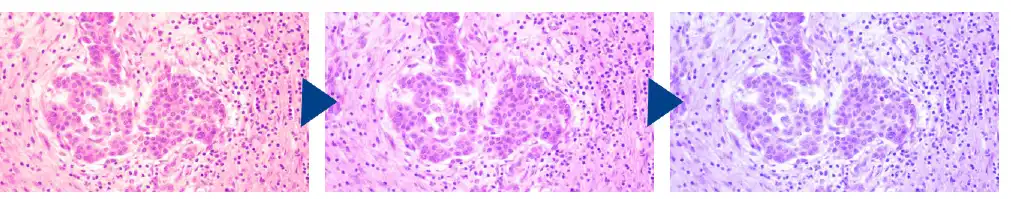
Color temperature adjustable

Nexcope Upright Biological Microscope NE710
Nexcope Upright Biological Microscope NE710
Phone:+86-21-54286005
Resources
 Nexcope NE710_Brochure-EN
Nexcope NE710_Brochure-EN

 Microsystem
Microsystem
 Endoscopysystem
Endoscopysystem
 Energysystem
Energysystem
 +86-21-54286005
+86-21-54286005
 info@tenmed.net
info@tenmed.net
 Room 602, Building 1, No. 111 Luxiang Road (Greenland Park Plaza), Baoshan District, Shanghai, China
Room 602, Building 1, No. 111 Luxiang Road (Greenland Park Plaza), Baoshan District, Shanghai, China

Nexcope Upright Biological Microscope NE710
Phone:+86-21-54286005
 Nexcope NE710_Brochure-EN
Nexcope NE710_Brochure-EN
The latest NE700 series microscope is designed for professional laboratory microscopic observation. On the one hand it has upgraded optical system , NIS infinity optics system provides excellent extendibility for this microscope,high numerical aperture (NA) plan achromatic objective and various types of optical components which have adopted multilayer coating technology could ensure the image quality. On the other hand, improving comfort and operation convenience continuously, and the LCD screen in front of the microscope displays real-time status of microscope during working, universal condenser, stopper that can be used to set the upper limit of the stage height etc., these structures ensure that beginners can use it smoothly. Ergonomic design helps you to stay focused for longer by reducing the strain on your body, which is the best choice for scientific research experimenters and medical examiners for microscopic observation.

NIS series plan achromatic objectives
NE700 employs NIS series plan archromatic objectives,which feature flat,sharp images up to the periphery of the field of view. High numerical aperture(NA) and long working distances,with high resolution, and a wide variety of usage are available.Restore the real colors and realize accurate observation of samples.

Observation with FOV of 22 mm
NE700 can enhance efficiency of sample observation when equipped with FOV22 tubes and lenses.

Kohler illumination,uniform brightness throughout the field of view
Adding a Kohler mirror in front of light source to provide bright and uniform field of view. Matching NIS infinity optical system and high-resolution objective,provides you perfect microscopic imaging.



Kohler Illumination Critical Illumination
Comfortable and worry free focus knob
Low position focus knob design,different areas on the specimen slide can be easily explored while resting your hands on the table,with adjustable torque could improve comfort . NE700 is equipped with a stopper that can be used to set the upper limit of the stage height, the stage stops at the set height even when the focus knob is turned, thereby eliminating the risk of over-focusing and breaking the slides or damaging the objectives.

Put Slide by one hand
Slides can be quickly slid in and out with one hand. The universal sample holder is suitable for a variety of slide types, such as Hemocytometer

Easy-to-rotate quintuple nosepiece
High-precision machining ensures smoothness and durability in use. The nosepiece features an easy grip for smooth rotation,and accommodates up to five objectives, users can also choose 2X objective with large field of view and phase contrast objectives.

Uniform and stable brightness
The LED light source produces daylight lighting conditions, so that the sample presents a natural color. LED design life span is 50,000 hours, which not only reduces maintenance costs, but also keeps the brightness stable during use.
Universal condenser is more convenient to use
Users can switch from 4X to 100X without moving the top lens.Contrast adjustment is performed by adjusting the iris diaphragm.

Status display
Using status including magnification,brightness,color temperature,stand by status are shown on the LCD which is in front of microscope


Smart design
Longtime microscope observation requires frequent magnification switching, brightness adjustment, color temperature adjustment, etc. NE700 simplifies these repetitive mechanical operations and reflected status on the LCD to improve work efficiency and provide comfortable user experience.
Maintains comfortable brightness when switching magnifications
NE700 features intelligent Light Intesity Management which automatically remembers and sets the light intensity level for wach objective, with this function, users can increase comfort and savetime when the routine requires frequent magnification changes.

Color temperature adjustable
The LED light source produces daylight lighting conditions, so that the sample presents a natural color. Since the color temperature can be changed according to observation demand, even if brightness is changed, the brightness and color temperature could keep users feel comfortable.
Realize various functions with one brightness control knob
Automatically power off after a period of inactivity
NE700 is equipped with an ECO mode which automaticlly turns off the illumination after a certaion period of inactivity, the length of the inactivity period is adjustable, with ECO mode, it helps you save power and extend microscope life.
Multifunctional digital head (optional)
Built-in camera device, supporting Android, iOS, Windows OS,both wired and WIFI are available. images can be shared in real time remotely via network.

Easier transportation and storage
NE700 equipped with special handle, which is light and good in stability and stable in structure. Its back board is designed with a hub device, which effectively accommodates excessive long power cords and improves cleanliness of the laboratory.
At the same time, it also reduces trip accidents caused by excessive long power cords during transportation.


